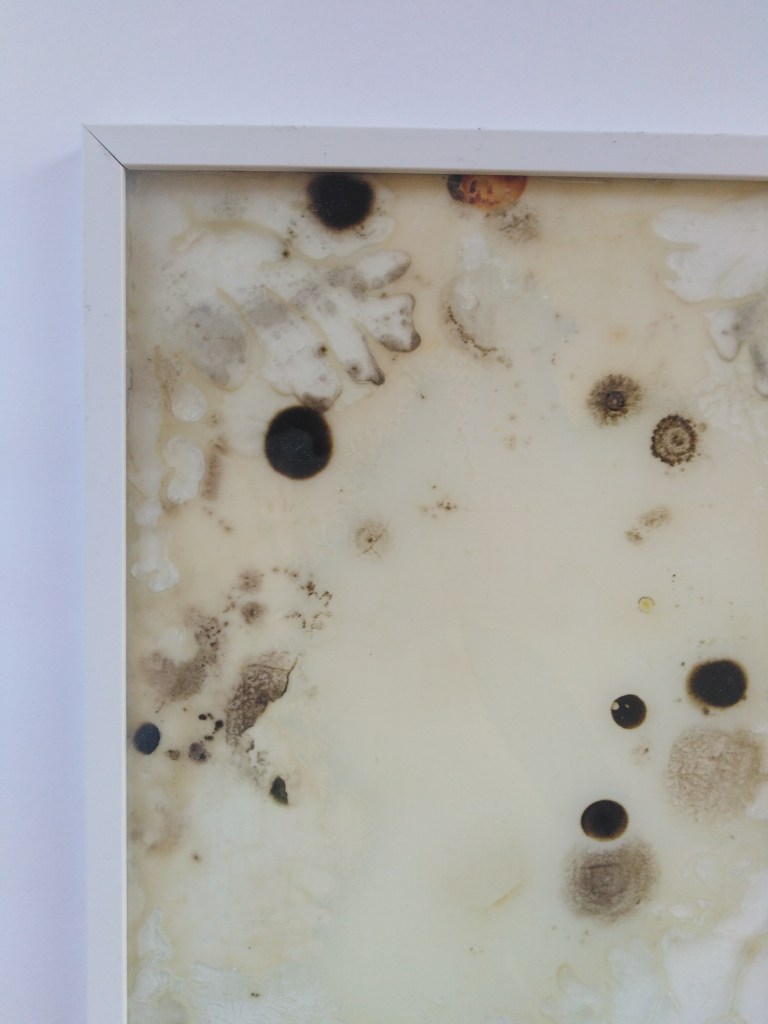

Les Vieilles, La descente de croix et La chute des damnés
j’expose des cultures de bactéries sous cadre. Mon intervention dans ce travail se cantonnant donc à la préparation du cadre et de la gelée nutritive, mais aussi – détail important – à la récolte d’échantillons. Ces prélèvements de germes viennent de tableaux de maîtres exposés au palais des beaux-arts de Lille, comme Les vieilles de Goya ou La descente de croix de Rubens. J’utilise une matière vivante présente à la surface de ce qui sont pour nous des images fixes inamovibles. Des particules symptomatiques d’une matérialité souvent occultée par l’aspect quasi mythique de ces tableaux. Pourtant c’est, je pense, l’une des raisons de l’admiration que l’on a pour les tableaux, ils sont des images et des objets qui traversant les époques et que des yeux plus vieux que nous de plusieurs siècles ont pu apprécier. Ainsi, les germes couvrant ces tableaux me semblent une métaphore pertinente de cette impalpable admiration que l’on peut ressentir face à des toiles de maître. Je remet alors en mouvement ces objets pour faire, comme dit Michel Blazy, “fleurir” une nouvelle image en espérant que celle-ci conserve un peu de l’aura de mysticisme de sa grande sœur.